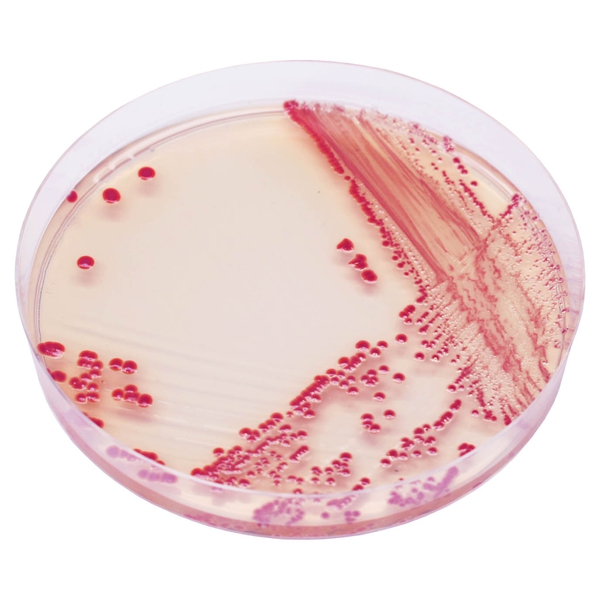
CHROMagar™ Acinetobacter

Hình thái khuẩn lạc

Acinetobacter spp.
đỏ

Các vi khuẩn Gram (-) khác
xanh hoặc hầu hết bị ức chế
Hiệu năng
Hiệu năng
Vi khuẩn phổ biến phân bố rộng rãi trong tự nhiên, Acinetobacter có khả năng sống sót ở cả môi trường khô và ẩm. Nó trở thành nguồn lây nhiễm trong môi trường bệnh viện khi xâm chiếm các thiết bị y tế, da người và đôi khi là đồ ăn. Các loài Acinetobacter thường không gây bệnh cho người khỏe mạnh nhưng có thể đe dọa tính mạng đối với những bệnh nhân bị suy giảm miễn dịch. Nó thường được phân lập trong các trường hợp nhiễm trùng bệnh viện, đơn vị chăm sóc đặc biệt, và có thể gây ra viêm phổi bệnh viện, nhiễm khuẩn huyết và viêm màng não.
Đặc biệt, Acinetobacter baumannii đang trở thành vấn đề lớn trong nhiễm trùng bệnh viện do thường có đa kháng thuốc (MDR: kháng C3G, quinolon, carbapenem, v.v.). Điều này góp phần tăng tỷ lệ mắc bệnh và tử vong.
Giám sát tích cực là cần thiết để kiểm soát sự lây lan của nó trong các cơ sở, giảm nguy cơ nhiễm chéo và xác định người mang mầm bệnh. Nhận dạng nhanh chóng các bệnh nhân bị xâm nhập bởi Acinetobacter sẽ dẫn đến các biện pháp kiểm soát nhiễm trùng nhằm ngăn chặn sự lây lan của vi sinh vật này.
Mục đích sử dụng :
CHROMagar™ Acinetobacter là môi trường nuôi cấy chromogen chọn lọc và phân biệt, được thiết kế để phát hiện trực tiếp sự xâm nhập của Acinetobacter nhằm hỗ trợ việc phòng ngừa và kiểm soát Acinetobacter, nhạy cảm với thuốc hoặc đa kháng thuốc (MDR), trong môi trường chăm sóc sức khỏe. Xét nghiệm được thực hiện với các mẫu gạc trực tràng, gạc mũi, gạc vết thương, phân và nước tiểu từ bệnh nhân để sàng lọc tình trạng xâm nhập Acinetobacter. Nó cũng có thể được sử dụng trong giám sát vệ sinh môi trường lâm sàng với việc lấy mẫu bề mặt. Kết quả có thể được diễn giải sau 18-24 giờ ủ hiếu khí ở 35-37 °C.
Môi trường cũng có thể được sử dụng như là một chỉ thị cảnh báo sớm cho các xét nghiệm chẩn đoán nhiễm trùng để báo hiệu khả năng có mặt của vi khuẩn kháng đa thuốc. Việc sử dụng này không thay thế các giao thức của tổ chức.
CHROMagar™ Acinetobacter không nhằm mục đích chẩn đoán nhiễm trùng Acinetobacter hay hướng dẫn hoặc theo dõi điều trị nhiễm trùng. Thiếu sự phát triển hoặc sự biến mất của các khuẩn lạc trên CHROMagar™ Acinetobacter không loại trừ sự hiện diện của Acinetobacter. Việc nhận dạng thêm, thử nghiệm độ nhạy và định kiểu dịch tễ học cần được thực hiện trên các khuẩn lạc nghi ngờ.
1. Màu đỏ đặc trưng : Phát hiện A. baumannii từ môi trường nuôi cấy truyền thống có thể là một nhiệm vụ khó khăn và tốn công sức do sự phong phú của vi hệ nền tìm thấy trong các mẫu thu thập, đặc biệt khi sử dụng môi trường dựa trên khả năng lên men lactose/không lên men lactose. Để vượt qua những khó khăn này, CHROMagar™ Acinetobacter được thiết kế như một môi trường chọn lọc cao, cho phép sự tăng trưởng của Acinetobacter trong các khuẩn lạc màu đỏ nổi bật, sau thời gian ủ qua đêm.

2. Môi trường chromogen độc đáo để phát hiện Acinetobacter.
3. Sàng lọc MDR Acinetobacter : Môi trường này có thể được bổ sung để tăng cường độ đặc hiệu MDR cho phép sự phát triển của các chủng kháng carbapenem.
Thành phần

Tài liệu kỹ thuật
Công bố khoa học
2024
Carbapenem-resistant Acinetobacter baumannii carrier detection: a simple and efficient protocol
📄 Publication2022
Evaluation of CHROMagar Acinetobacter and MacConkey media for the recovery of Acinetobacter baumannii from soil samples
📄 Publication2022
Multidrug resistant bacteria on air, inanimate surface and medical equipment in an intensive care unit in Lima, Peru
📄 Publication2014
Laboratory evaluation of different agar media for isolation of carbapenem-resistant Acinetobacter spp.
📄 Publication2011
Modifications to CHROMagar Acinetobacter for improved selective growth of multi-drug resistant Acinetobacter baumannii
📄 Publication2021
Primer reporte de aislamiento de Klebsiella pneumoniae con doble carbapenemasa y resistencia a colistina en paciente con Covid-19
📄 Publication2016
Evaluation of Carriage and Environmental Spread of Carbapenem-Resistant Acinetobacter baumannii
📄 Publication2016
Occurrence of Acinetobacter calcoaceticus-baumannii complex in Municipal Wastewater
📄 Publication2016
Comparison of three diagnostic methods for Acinetobacter baumannii isolated from Baghdad Hospitals
📄 Publication2015
Culture media for detection of Acinetobacter baumanii Selective Media for Detection of A baumanii
📄 Publication2013
Carbapenem resistance in Acinetobacter baumannii: laboratory challenges, mechanistic insights and therapeutic strategies
📄 Publication2013
Modified CHROMagar Acinetobacter Medium for Direct Detection of Multidrug-Resistant Acinetobacter Strains in Nasal and Rectal Swab Samples
📄 Publication2012
Evaluation of CHROMagar Acinetobacter™ for detection of multi-resistant Acinetobacter baumannii in clinical specimens
📄 Publication2012
Variations of CHROMagar Acinetobacter to detect imipenem-resistant Acinetobacter baumannii – calcoaceticus complex
📄 Publication2011
CHROMagar Acinetobacter media for detection of multidrug resistant (MDR) Acinetobacter in Surveillance cultures
📄 Publication2011
Detection of Multi-drug resistant Acinetobacter baumannii (MDR-AB) in Peri-Rectal Surveillance Cultures of Critically Ill Patients for Infection Control
📄 Publication2011
Evaluation of a novel selective medium, CHROMagar™ Acinetobacter with KPC supplement, for detection of multidrug-resistant Acinetobacter baumannii from clinical specimens in Japan
📄 Publication2010
Overnight identification of imipenem-resistant Acinetobacter baumannii carriage in hospitalized patients
📄 Publication

Xem thêm